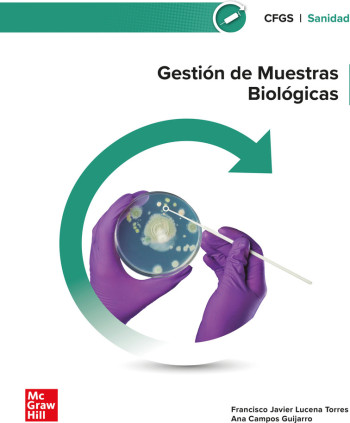
GESTION DE MUESTRAS BIOLOGICAS

Gastos de envío gratis a partir de 25€
Los gastos de envío y/o gestión no están comprendidos en el precio y te serán mostrados antes de finalizar tu compra, en función de la dirección de envío de cada pedido. Los costes de envío a Canarias, Ceuta, Melilla y zonas no pertenecientes a la Unión Aduanera Europa no incluyen los costes (aranceles) de importación, que serán pagados en metálico en destino por el receptor de la mercancía.
Devoluciones. Derecho de desistimiento.
Puedes devolver tus compras sin dar explicaciones hasta 15 días naturales después de haber recibido tu pedido.
Recibirás el reembolso del importe de los productos así como de los gastos de envío iniciales (si los hubiera) en un plazo máximo de 14 días naturales desde la recepción de la devolución en nuestro almacén.
En caso de que la devolución no se deba a un error provocado por hersolibros.es deberás asumir el coste de hacernos llegar la mercancía. Consúltanos si necesitas ayuda.
Si la devolución se debe a un error nuestro, ponte en contacto con nosotros cuanto antes y lo solucionaremos con la mayor celeridad posible.

Consulta aquí los gastos de envío